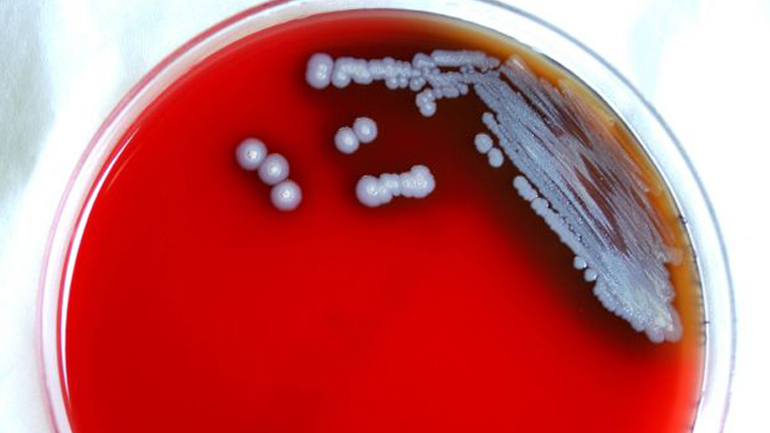
ΗΠΑ: Βακτήρια που προκαλούν σπάνια αλλά θανατηφόρα λοίμωξη εντοπίστηκαν στον Μισισιπή

ΗΠΑ: Βακτήρια που προκαλούν σπάνια αλλά θανατηφόρα λοίμωξη εντοπίστηκαν στον Μισισιπή
Οι αμερικανικές υγειονομικές αρχές ανακοίνωσαν την Πέμπτη, ότι σε δειγματοληψίες εδάφους και νερού από τον...
28/07/2022 | 03:11